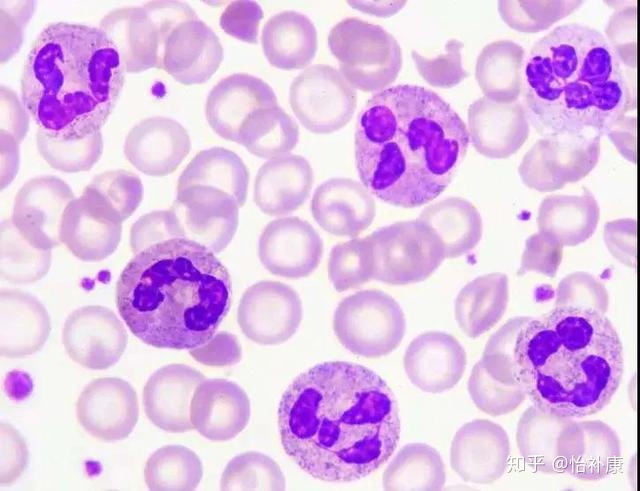

主页 > 性病学术 > 艾滋病
-

震惊!广西大学生艾滋病数据曝光,感染最多的竟是他们
点击标题下「爱南宁」可快速关注看完这个消息,小爱是震惊的,恋爱有风险,搞基需谨慎,同性不会怀孕,但是还是要戴套啊!广西官方公布艾滋病疫情数据,10年前吸毒是艾滋病传播主要途
-

艾滋病毒携带者允许报考公务员
《公务员录用体检通用标准(试行)》第二稿中,对一稿最大的修改之一便是取消了艾滋病毒携带者不合格的限制规定。 在国家人事部对《公务
-

25名艾滋病急性期,病人自述总结快来看看
感染艾滋病最主要的是由于无保护措施的性行为。不洁身自爱,滥交都容易感染艾滋病。很多人都以为艾滋病离自己很远,其实,要做好这些防范,看似简单也不简单,难也不难。
-

HIV阳性家庭,如何生一个健康的宝宝?
hiv夫妻双方均为HIV阳性或者有一方为阳性,想要生一个健康宝宝可以吗? 疑虑 “HIV 感染者可以生小孩吗?”“孩子将来会是健康的吗?”夫妻双方均为HIV阳性或者有一方为阳性
-
艾滋病病毒(HIV)感染后的自然过程和临床分期
1、HIV感染后的自然过程(1)急性感染期这种急性感染通常发生在接触艾滋病病毒后1~2周左右。在急性感染期内,HIV大量复制而CD4细胞急剧下降。
-

艾滋病试纸自测几次可排除感染
用艾滋病试纸自测艾滋病,需要检测几次才可以排除感染?看看下面文章的介绍。
-

【艾滋病】艾滋病是什么
艾滋艾滋病是由于感染了艾滋病病毒,是一种极强的传染病,对于人的身体危害及其他,潜伏期和爆发期都很不稳定,死亡率非常高病。主要的传播途径为性接触传播、血液传播、母婴传播
-

艾滋病病毒有哪些特点
HIV病毒主要攻击人体的辅助T淋巴细胞系统;一旦侵入机体细胞
-
艾滋的潜伏期让人捉摸不透?这6个其实就是暗号
虽然说现在的医学水平有很大的提高,一些疾病能够得到有效的控制,但是也存在着一些疾病,不能够被完全治愈,比如说艾滋病,艾滋病是临床上十分常见的传染性疾病,这种传染性疾病危害程度高。出现之后容易破坏人的免疫系统,将淋巴细胞作为主要的攻击目标,淋巴细胞受到破坏时免疫功能持续下降,各种不良症状就会出现。因此
-
梅毒案例:如何判断自己是否患了梅毒
梅毒几乎都是由于亲密接触一期或二期梅毒损害(硬下疳、黏膜斑、扁平湿疣)而被传染的,本文将通过一个梅毒案例,一位患者的求助来介绍如何判断自己是否患梅毒。
-
二期梅毒皮肤上会起疙瘩和脓疱吗
二期梅毒患者出现斑疹后约3周在身体多个部位就会出现疙瘩皮疹,造成较高的误诊率。那么今天我们就来了解一下二期梅毒皮肤会发生什么样的疙瘩和脓疱。
-
哪些人群必须进行艾滋病检测
艾滋病毒是人类的头号大敌,理想状态,每个人都需要定期做艾滋病检测,这是有效预防艾滋病毒传播的关健所在,但由于种种条件的限制,暂时无法做到这一点。艾滋病的传播途径有三种,分别是性途径传播、血液途径传播、母婴传播,因此,以下高危人群将需要做艾滋病检测。

